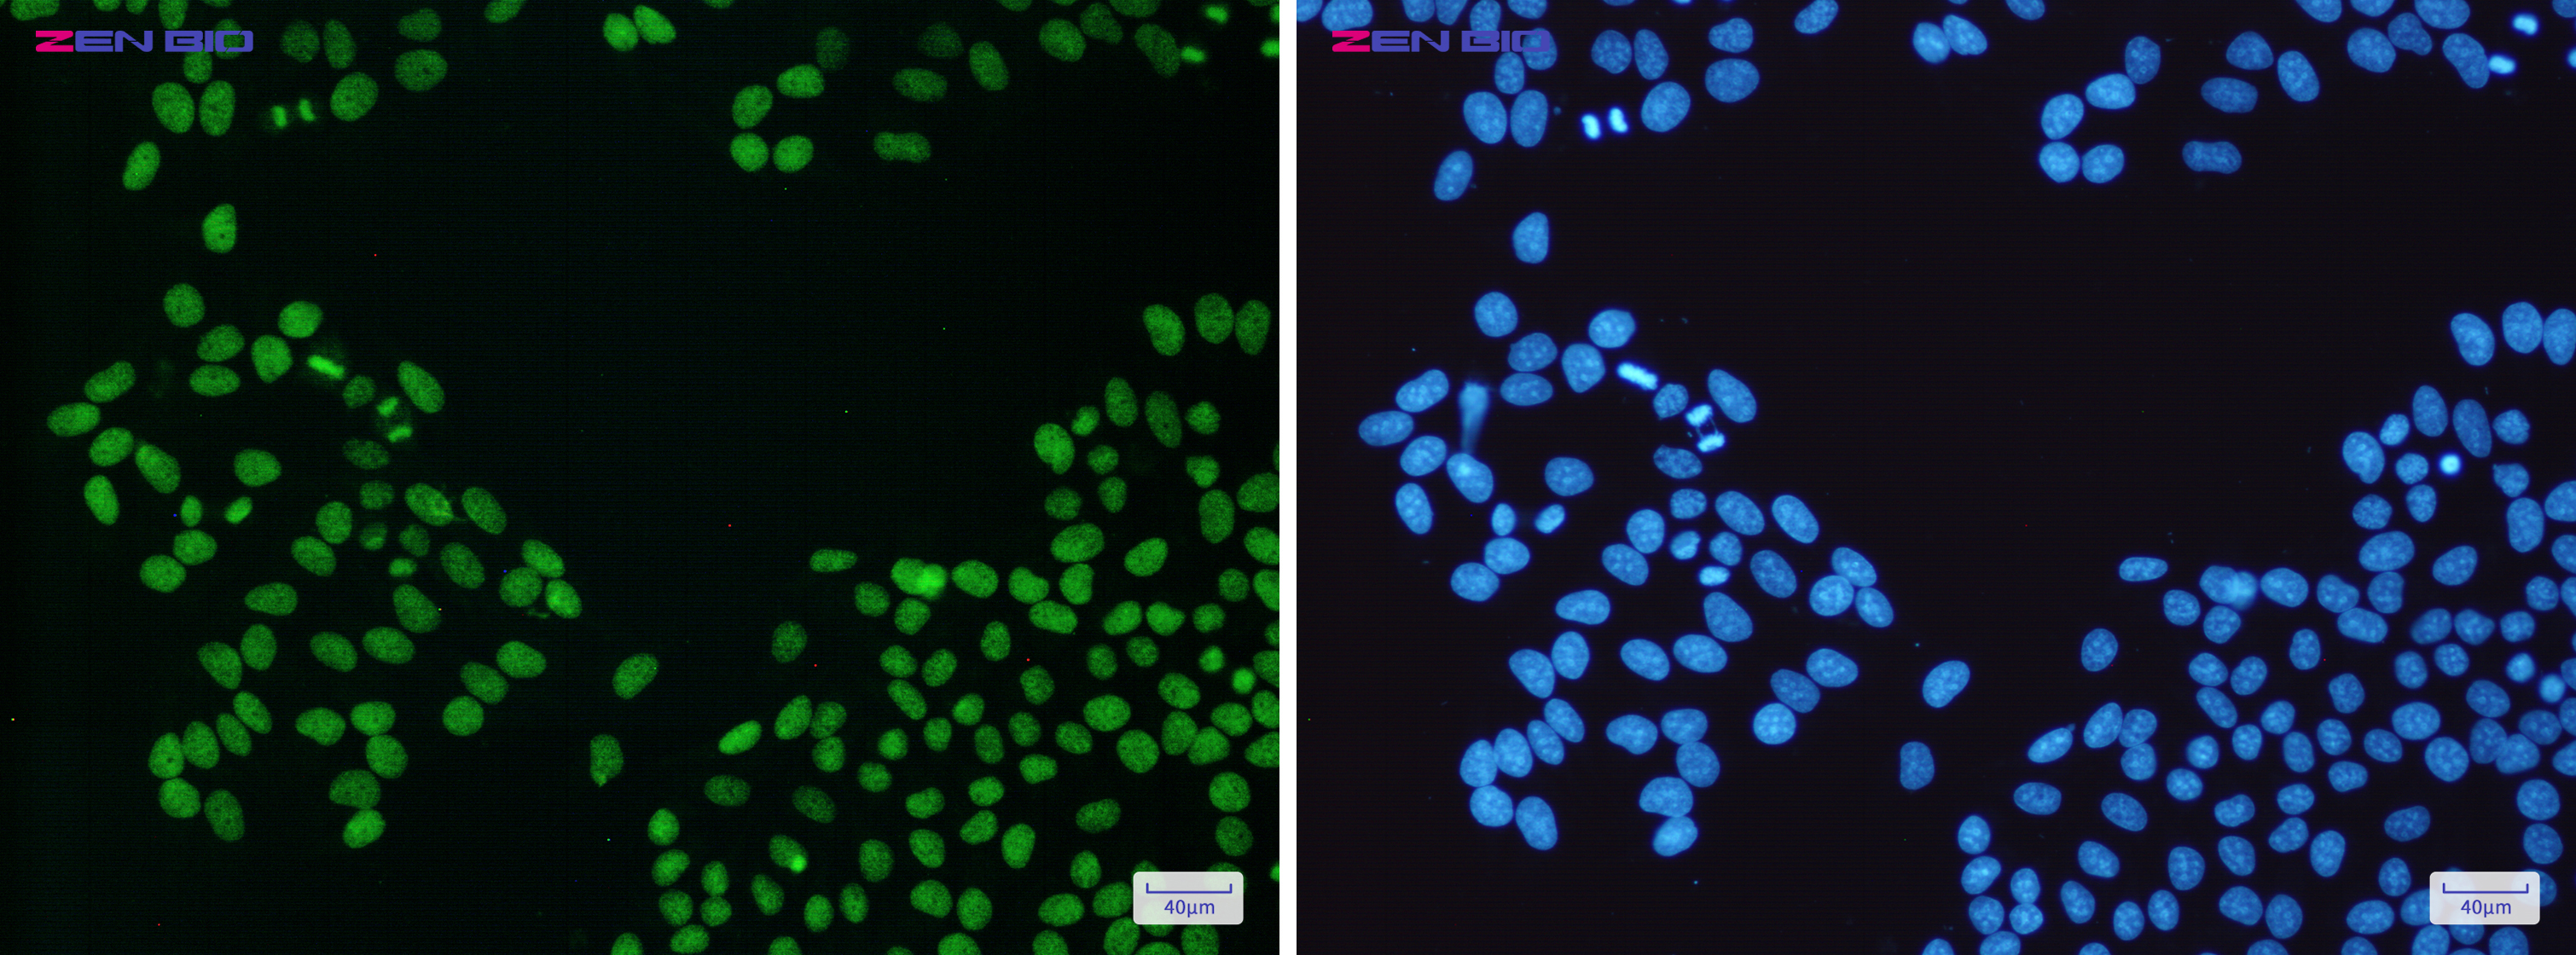

-
Product Name
Anti-PARP1 Rabbit antibody
- Documents
-
Description
PARP1 Rabbit polyclonal antibody
-
Tested applications
WB, IHC-P, ICC/IF
-
Species reactivity
Human, Mouse, Rat
-
Alternative names
PARP; PPOL; ADPRT; ARTD1; ADPRT1; PARP-1; ADPRT 1; pADPRT-1 antibody
-
Isotype
Rabbit IgG
-
Preparation
Antigen: A synthetic peptide of human PARP1
-
Clonality
Polyclonal
-
Formulation
Supplied in 50nM Tris-Glycine(pH 7.4), 0.15M Nacl, 40%Glycerol, 0.01% sodium azide and 0.05% BSA.
-
Storage instructions
Store at -20°C. Stable for 12 months from date of receipt.
-
Applications
WB: 1/1000
IHC: 1/200
ICC/IF: 1/50
-
Validations

Western blot detection of PARP1 in K562,3T3,Hela cell lysates using PARP1 Rabbit pAb(1:1000 diluted).Predicted band size:113kDa.Observed band size:116/89kDa.
Immunocytochemistry of PARP1(green) in Hela cells using PARP1 Rabbit pAb at dilution 1/50, and DAPI(blue)

Immunohistochemistry of PARP1 in paraffin-embedded Human tonsil using PARP1 Rabbit pAb at dilution 1/50
-
Background
Swiss-Prot Acc.P09874.Involved in the base excision repair (BER) pathway, by catalyzing the poly(ADP-ribosyl)ation of a limited number of acceptor proteins involved in chromatin architecture and in DNA metabolism. This modification follows DNA damages and appears as an obligatory step in a detection/signaling pathway leading to the reparation of DNA strand breaks (PubMed:17177976, PubMed:18172500, PubMed:19344625, PubMed:19661379, PubMed:23230272). Mediates the poly(ADP-ribosyl)ation of APLF and CHFR (PubMed:17396150). Positively regulates the transcription of MTUS1 and negatively regulates the transcription of MTUS2/TIP150. With EEF1A1 and TXK, forms a complex that acts as a T-helper 1 (Th1) cell-specific transcription factor and binds the promoter of IFN-gamma to directly regulate its transcription, and is thus involved importantly in Th1 cytokine production (PubMed:17177976). Required for PARP9 and DTX3L recruitment to DNA damage sites (PubMed:23230272). PARP1-dependent PARP9-DTX3L-mediated ubiquitination promotes the rapid and specific recruitment of 53BP1/TP53BP1, UIMC1/RAP80, and BRCA1 to DNA damage sites (PubMed:23230272). Mediates serine ADP-ribosylation of target proteins following interaction with HPF1; HPF1 conferring serine specificity (PubMed:28190768). Mediates the poly(ADP-ribosyl)ation of histones in a HPF1-dependent manner (PubMed:27067600). Involved in the synthesis of ATP in the nucleus, together with NMNAT1, PARG and NUDT5 (PubMed:27257257). Nuclear ATP generation is required for extensive chromatin remodeling events that are energy-consuming (PubMed:27257257).
Related Products / Services
Please note: All products are "FOR RESEARCH USE ONLY AND ARE NOT INTENDED FOR DIAGNOSTIC OR THERAPEUTIC USE"
